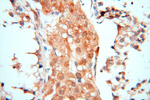
CBLB Antibody in Immunohistochemistry (Paraffin) (IHC (P))

Search
Proteintech
CBLB Polyclonal Antibody
{{$productOrderCtrl.translations['antibody.pdp.commerceCard.promotion.promotions']}}
{{$productOrderCtrl.translations['antibody.pdp.commerceCard.promotion.viewpromo']}}
{{$productOrderCtrl.translations['antibody.pdp.commerceCard.promotion.promocode']}}: {{promo.promoCode}} {{promo.promoTitle}} {{promo.promoDescription}}. {{$productOrderCtrl.translations['antibody.pdp.commerceCard.promotion.learnmore']}}
产品信息
12781-1-AP
种属反应
已发表种属
宿主/亚型
分类
类型
抗原
偶联物
形式
浓度
规格
纯化类型
保存液
内含物
保存条件
运输条件
产品详细信息
Immunogen sequence: MANSMNGRN PGGRGGNPRK GRILGIIDAI QDAVGPPKQA AADRRTVEKT WKLMDKVVRL CQNPKLQLKN SPPYILDILP DTYQHLRLIL SKYDDNQKLA QLSENEYFKI YIDSLMKKSK RAIRLFKEGK ERMYEEQSQD RRNLTKLSLI FSHMLAEIKA IFPNGQFQGD NFRITKADAA EFWRKFFGDK TIVPWKVFRQ CLHEVHQISS GLEAMALKST IDLTCNDYIS VFEFDIFTRL FQPWGSILRN WNFLAVTHPG YMAFLTYDEV KARLQKYSTK PGSYIFRLSC TRLGQWAIGY VTGDGNILQT IPHNKPLFQA LIDGSREGFY LYPDGRSYNP DLTGLCEPTP HDH (1-352 aa encoded by BC032851)
靶标信息
This gene encodes a protein of unknown function. The protein contains a bromodomain, a sequence motif often found in transcriptional coactivators, and localizes to the nucleus in testis and several other cell types.
仅用于科研。不用于诊断过程。未经明确授权不得转售。
生物信息学
蛋白别名: Cas-Br-M (murine) ecotropic retroviral transforming sequence b; Cas-Br-M (murine) ectropic retroviral transforming sequence b; Casitas B-lineage lymphoma b; Casitas B-lineage lymphoma proto-oncogene b; Cbl proto-oncogene B, E3 ubiquitin protein ligase; Cbl proto-oncogene, E3 ubiquitin protein ligase B; E3 ubiquitin-protein ligase CBL-B; RING finger protein 56; RING-type E3 ubiquitin transferase CBL-B; SH3-binding protein CBL-B; Signal transduction protein CBL-B; unnamed protein product
基因别名: ADMIO3; AI429560; AI851073; Cbl-b; CBLB; Nbla00127; RNF56
UniProt ID: (Human) Q13191, (Rat) Q8K4S7, (Mouse) Q3TTA7
Entrez Gene ID: (Human) 868, (Rat) 171136, (Mouse) 208650